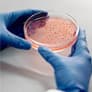
Microbiology
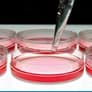
ready to use media

Convenience
Shop products from multiple brands in a single order.
Trusted Platform
Customers from 500+ Indian cities and 50+ countries
Quality
Assured
5000+
Genuine Chemical Products
Convenience
Shop products from multiple brands in a single order.
How it Works
For Buyers
Step-by-Step Process
Easily search for manufacturers in your area.
Get listed manufacturer details for quick connections.
Fill out a simple enquiry form to get in touch.
Tell us what you're looking for to find the perfect match.
For Suppliers
Step-by-Step Process
Showcase your products to a worldwide audience.
Establish direct connections with interested customers.
Receive authentic inquiries from verified buyers.
Simple registration and product listing process.
High Demand Lab Chemicals
- Acids & Solvents
- Pharmaceutical Chemical
- Lab Glassware
- Culture-Media

₹ 4290
-Abscisic-acid-RM769-500MG.jpg&w=640&q=75)
()-Abscisic acid-RM769-500MG
₹ 32,590

Acetonitrile, HPLC-AS028-2.5L
₹ 4120

Tannic acid-PCT1549-250G
₹ 4625

Tannic acid-PCT1549-500G
₹ 8300

Acetonitrile, HPLC-AS028-1L
₹ 1920

Boric acid-PCT0102-1KG
₹ 1745
GET IN TOUCH WITH US
For the listing or any technical support, please feel free to contact us or fill out the form.
Visit: chembeez.com
Call us at: +91-7347019449
Write to us: support@chembeez.com
Brands we deal





Laboratory Supplies, Equipment, & Biotechnology Products in India
Chembeez is India's first and only online portal dedicated to supplying a vast range of chemical and life science products.
If you're working in a biotechnology or chemistry laboratory within academia, industry, or corporations, Chembeez is your ideal resource. This B2B e-commerce marketplace hosts over 100,000 products across 100+ categories from 100+ national and international brands. Simply select your desired products online, compare prices and features, and place your order. Our platform streamlines the process, ensuring timely delivery to keep your experiments and research on track.
Chembeez partners with leading manufacturers and suppliers nationwide to connect them with potential clients. Suppliers can list their inventory at competitive prices, benefiting researchers with cost-effective product access. We offer solutions, reagents, chemicals, glassware, and biotech products for genomics, proteomics, microbiology, chemistry, molecular biology, cell culture, and more. Explore our website for special offers, package deals, and create an account to connect with our live support team.
- Lab Glassware :-
- Laboratory Bottles Caps & Accessories |
- General Laboratory Glassware |
- Filtration Products |
- Laboratory Accessories |
- Quartzware & Sintered Ware |
- View All
- Culture Media :-
- Dehydrated Culture Media |
- Microbial Culture Media |
- Harmonized Culture Media |
- Biological Media Bases |
- Plant Tissue Culture Media |
- View All
- Pharmaceutical Chemical :-
- Absolute Ethanol |
- Acetic Acid (CH3COOH) |
- Acetone |
- Ammonia Solutions (NH4OH) |
- View All
- Acids & Solvents:-
- Acetic Acid |
- Acetone |
- Ethyl Acetate |
- View All
Copyright 2025 - All Rights Reserved.